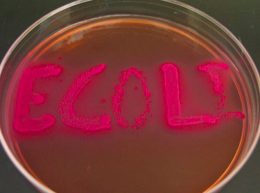
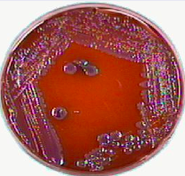
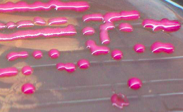
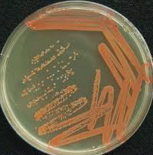
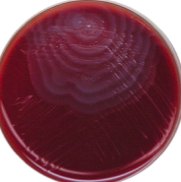

pink indicates which feature of E coli?
lactose fermenter
usually with predisposing condition, large polysaccharide capsule defends against phagocytosis/complement, adhesins adhere to gut cells, siderophores chelate iron

Klebsiella
________ on eosin methylene blue agar: slightly selective for Gram -
opportunistic, rarely causes dz in previously healthy pt
enterobacter
mucoid appearance of _____
Klebsiella
red colonies of _____
serratia
swarming rings of _____ in blood agar
Proteus
catalase -, grow in high salt, normal GI flora, opportunistic pathogen, resistance to ABs

enterococcus